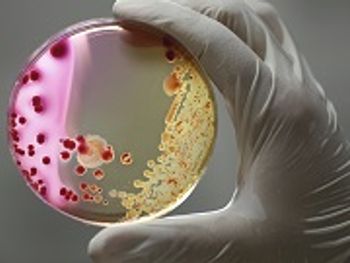

C. difficile
Latest News

Latest Videos

CME Content
More News

Through investigating a type of toxin released by the most dangerous strains of C. diff, researchers now have a map for developing drugs that can block the toxin and prevent the bacteria from entering human cells.

The findings reveal a unique mechanism for C.diff survival in the human gut and suggest novel strategies for weakening its defenses, according to the study authors.

Although clostridioides difficile is the leading cause of health care-associated infection in the United States, there are currently only 2 antibiotics available for its treatment: vancomycin and fidaxomicin.

Findings show that an inflamed environment allows clostridioides difficile to thrive in an environment that is inhospitable to competing bacteria.

Fecal microbiota transplants (FMT) are highly successful in treating patients with Clostridioides difficile (C diff) infections, according to a study by the University of Birmingham.

The change in guidelines address how to assess damage to the kidneys caused by fluid loss associated with severe C. diff infection.

A commonly used drug made from secondary bile acids can affect the life cycle of Clostridioides difficile.

Fidaxomicin is a macrolide antibacterial medicine indicated to be used to treat infections that are proven or strongly suspected to be caused by C. difficile.

The easiest way to avoid misdiagnosis, inappropriate treatment, and potential loss of reimbursement is to prevent unsuitable testing.

A first-in-human trial evaluating the safety, pharmacokinetics, and fecal microbiome effects of a novel DNA polIIIC inhibitor demonstrated the antibacterial’s promise as a potential treatment alternative to vancomycin for the treatment of Clostridioides difficile.

Hospital-onset C. difficile infection decreased after implementing daily cleaning, health care worker hand hygiene, patient hand hygiene, screening at admission, and patient transfer reduction.

Vancomycin hydrochloride may reduce the burden on pharmacists treating patients with Clostridium Difficile.

The study found patients who were prescribed antibiotics for dental procedures tended to be older and more likely to receive clindamycin, an antibiotic that is associated with C diff infection.

Sharp Spike Underscores Need for New Treatments
Clostridium difficile (C. difficile) infections could be a cause of travel-associated diarrhea.

Hospitalized patients with Clostridium difficile (C. difficile) infection are at an increased risk of colonization if they are considered frail.

A majority of the children with C. difficile were prescribed at least 1 antibiotic in the 12 weeks leading up to their diagnosis.

A recently-published study in JAMA suggests that Clostridium difficile may be more effectively treated with vancomycin than its more commonly used counterpart metronidazole.

Using bezlotoxumab lowers the rate of recurrent Clostridium difficile infection more than a placebo alone, according to results of 2 phase 3 trials published this week in the New England Journal of Medicine.

Roche's new tests to detect Clostridium difficile and genital herpes infection have been cleared by the FDA.

Clostridium difficile-associated diarrhea (CDAD) is an increasingly common cause of inpatient mortality, and recurrent CDAD remains clinically challenging.

The US Centers for Disease Control and Prevention today reported that nearly half a million Clostridium difficile infections occurred in a single year, highlighting a critical need for improved antibiotic use.































